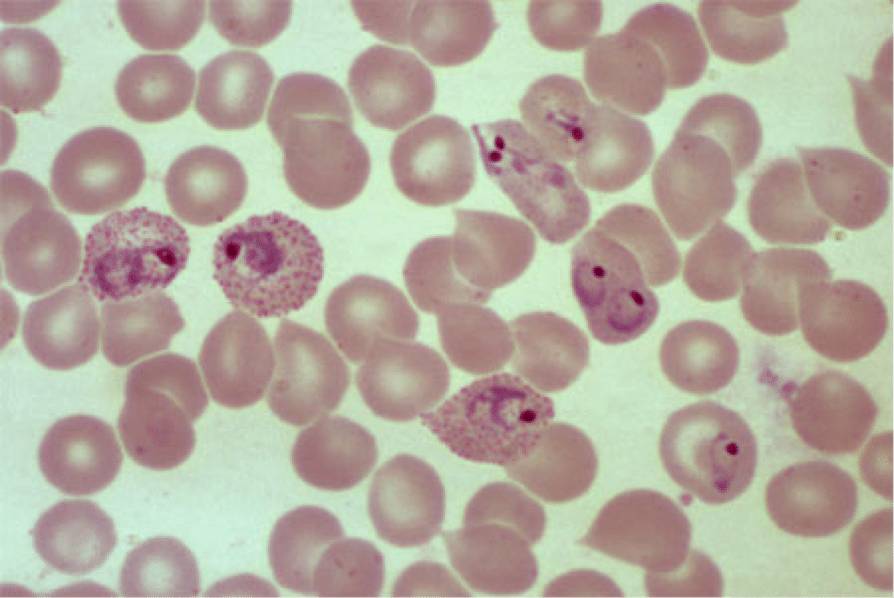
Кровь под микроскопом

Кто вызывает болезнь?
Малярию у человека вызывают плазмодии — одноклеточные организмы. Существует четыре основных вида, способных вызывать это заболевание у людей. Недавно был обнаружен еще один потенциально опасный вид плазмодия, который встречается в некоторых азиатских странах.
Жизненный цикл возбудителя малярии включает несколько этапов:
- Паразитирование на самке малярийного комара;
- Проникновение в организм человека на ранней стадии (после укуса комара);
- На протяжении некоторого времени спорозоиты находятся в лимфе и крови, где продолжают развиваться;
- Проникновение в клетки печени (на этом этапе начинается доклиническая печеночная стадия заболевания, а для паразитов — инкубационный период);
- Спорозоиты развиваются в шизонты (взрослые формы);
- Запускается шизогония — процесс бесполого размножения, в результате которого образуется множество мерозоитов, которые вскоре снова попадают в кровь;
- Длительность печеночного цикла варьируется в зависимости от вида паразита (иногда мерозоиты могут оставаться в печени на протяжении многих лет, вызывая периодические рецидивы);
- Мерозоиты, попавшие в кровь или лимфу, прикрепляются к рецепторам на мембранах эритроцитов.
С этого момента начинается развитие инфекции, и появляются первые симптомы малярии, такие как повышение температуры и озноб. Продолжительность инкубационного периода будет различаться в зависимости от вида паразита.
Врачи отмечают, что малярия остается одной из серьезных инфекционных болезней, особенно в тропических и субтропических регионах. Симптомы заболевания могут варьироваться, но чаще всего проявляются в виде высокой температуры, озноба, головной боли и мышечной боли. Важно помнить, что эти признаки могут напоминать грипп, что затрудняет диагностику на ранних стадиях.
Специалисты подчеркивают, что своевременное обращение за медицинской помощью критически важно, так как запущенные случаи могут привести к серьезным осложнениям. Лечение малярии включает применение антималярийных препаратов, таких как хлорохин и артемизинин, однако выбор терапии зависит от типа паразита и степени тяжести заболевания. Врачи также акцентируют внимание на профилактике, включая использование москитных сеток и репеллентов, что значительно снижает риск заражения.

Пути заражения
Большинство путешественников, планируя поездки в регионы с неблагоприятной эпидемиологической ситуацией (например, в некоторых странах Африки и Азии), часто интересуются, каким образом можно заразиться инфекцией и как этого избежать. Все способы передачи малярии можно классифицировать на три основные группы:
- Заражение через укус малярийного комара. Это наиболее распространенный способ. Инфекция происходит, когда самка малярийного комара, высасывая кровь, вводит в организм теплокровного существа паразита из рода плазмодиев. Комар выступает в роли первичного носителя, передавая паразита второму носителю – млекопитающему, во время укуса;
- Трансплацентарный путь передачи, который подразумевает передачу клинических форм малярии от зараженной беременной женщины к ее ребенку через плаценту. Этот способ не так часто встречается в странах, где малярия не распространена, поскольку беременные женщины обычно избегают поездок в регионы с высоким риском заболевания. Однако среди коренного населения таких мест этот путь передачи довольно распространен. Инфекция может произойти, если женщина заразилась во время беременности или забеременела в инкубационный период;
- Парентеральный путь передачи от инфицированного человека, который осуществляется через переливание крови, использование нестерильных игл и подобные методы.
Более подробно об этом можно узнать в статье: «Как передается малярия?».
Других способов передачи малярии не существует. Понимание природы малярии позволяет сделать выводы о путях ее распространения. Она не передается воздушно-капельным путем, как многие другие инфекции, так как возбудители находятся в клетках крови.
| Аспект | Описание | Важные особенности |
|---|---|---|
| Симптомы | Лихорадка (часто приступообразная), озноб, головная боль, мышечные боли, тошнота, рвота, диарея, утомляемость. В тяжелых случаях: судороги, кома, анемия, желтуха, почечная недостаточность. | Симптомы могут быть неспецифичными, особенно на ранних стадиях, что затрудняет диагностику. Приступы лихорадки могут иметь определенную периодичность (например, каждые 48 или 72 часа) в зависимости от вида плазмодия. |
| Особенности | Передается через укусы инфицированных комаров рода Anopheles. Вызывается паразитами рода Plasmodium (P. falciparum, P. vivax, P. ovale, P. malariae, P. knowlesi). Инкубационный период от 7 дней до нескольких месяцев. | P. falciparum является наиболее опасным видом, вызывающим тяжелые формы малярии и высокую смертность. P. vivax и P. ovale могут вызывать рецидивы через месяцы или годы после первичного заражения из-за спящих форм паразита в печени (гипнозоитов). |
| Лечение | Противомалярийные препараты (например, артемизинин-комбинированная терапия (АКТ), хлорохин, мефлохин, примахин). Выбор препарата зависит от вида плазмодия, географического региона (устойчивость к препаратам) и состояния пациента. | Важно начать лечение как можно раньше. Самолечение недопустимо. Для предотвращения рецидивов при P. vivax и P. ovale требуется дополнительный курс примахина (или тафенохина) для уничтожения гипнозоитов. |
Виды
Существует несколько разновидностей малярии. Тип заболевания, который разовьется у пациента, зависит от вида плазмодия, вызвавшего инфекцию. Разные формы малярии имеют свои особенности течения, что влияет не только на симптомы, но и на продолжительность болезни и ее прогноз. Важно определить тип заболевания до начала лечения, так как подходы к терапии могут различаться.
На сегодняшний день выделяют четыре основных типа малярии:
- Тропическая малярия, вызванная паразитом Плазмодиум Фальципарум, является наиболее распространенной формой, составляющей около 90% всех случаев. Она характеризуется тяжелыми симптомами и высокой вероятностью осложнений, что делает ее особенно опасной. Смертность среди пациентов с этой формой малярии также значительно выше;
- Четырехдневная малярия, вызванная паразитом Плазмодиум Маляриа, проявляется менее выраженно, чем тропическая. Симптомы имеют приступообразный и рецидивирующий характер, а название связано с тем, что приступы, как правило, возникают каждые три дня;
- Трехдневная малярия, вызываемая паразитом Плазмодиум Вивакс, по своим проявлениям схожа с предыдущей формой. Она также имеет приступообразное течение, но приступы возникают через 40-48 часов;
- Овале-малярия практически идентична по течению, симптомам и длительности инкубационного периода предыдущей форме, однако вызывается другим паразитом – Плазмодиум Овале.
Стадии развития плазмодиев различного типа имеют свои особенности и отличаются по продолжительности, что и обуславливает различия в течении заболевания.
Малярия — это инфекционное заболевание, вызываемое паразитами рода Plasmodium, которые передаются через укусы зараженных комаров. Симптомы малярии могут варьироваться, но чаще всего включают лихорадку, озноб, головную боль, мышечные боли и усталость. В некоторых случаях болезнь может привести к серьезным осложнениям, таким как анемия или повреждение органов. Люди, сталкивающиеся с малярией, подчеркивают важность профилактики, включая использование москитных сеток и репеллентов. Лечение обычно включает противомалярийные препараты, такие как хлорохин или артемизинин, однако устойчивость паразитов к лекарствам становится все более распространенной проблемой. Поэтому ранняя диагностика и правильное лечение имеют решающее значение для успешного выздоровления.

Симптомы
Многие люди, заметив укус комара на носу или подбородке после поездки в тропики, начинают интересоваться, как проявляется малярия и какие признаки характерны для ее начальной стадии. Обычно после заражения можно наблюдать следующие симптомы:
- Лихорадка (значительное повышение температуры тела до 39 градусов и выше);
- Озноб (это один из первых признаков малярии);
- Боль в суставах (артралгия);
- Тошнота и рвота;
- Анемия (при анализе мочи можно обнаружить гемоглобин, что указывает на его низкое содержание в крови);
- Конвульсии;
- Некоторые виды паразитов могут вызывать покалывания на коже;
- При медицинском осмотре может быть выявлена увеличенная селезенка (но это не всегда так);
- Сильная головная боль, которая плохо поддается лечению анальгетиками;
- Ишемия головного мозга (не всегда наблюдается).
У взрослых мужчин и женщин риск смертельного исхода ниже, чем у беременных женщин и детей, которые являются наиболее уязвимыми группами. У детей симптомы малярии могут проявляться особенно тяжело.
Когда у детей или взрослых появляются характерные признаки малярии, важно провести лабораторные исследования для подтверждения диагноза. Он ставится в случае обнаружения малярийного паразита в мазках крови. Диагностика не только позволяет установить факт заражения, но и помогает определить тип плазмодия, что необходимо для назначения наиболее эффективного лечения.
Последствия
Малярия: последствия и побочные эффекты
Малярия — это заболевание, которое вызывает множество вопросов у тех, кто его перенес. Интересует ли вас, какие последствия могут возникнуть помимо основных симптомов? Это заболевание характеризуется серьезными проявлениями, такими как высокая температура и риск ишемии головного мозга. Также существует вероятность развития малярийной комы и разрыва селезенки.
Последствия малярии могут варьироваться в зависимости от типа паразита, вызвавшего инфекцию. Они могут проявляться в течение нескольких лет после перенесенной болезни, так как в печени могут оставаться молодые формы паразитов. Поэтому каждому, кто переболел малярией, рекомендуется находиться под наблюдением в течение двух лет после выздоровления. Важно регулярно проходить анализы на наличие плазмодия в крови. Это позволит своевременно выявить и предотвратить возможные последствия малярии.

Иммунитет
Как известно, после перенесенной инфекции организм формирует иммунитет, который может быть как временным, так и постоянным, что делает повторное заражение в короткие сроки невозможным. Однако малярия в этом плане представляет собой исключение. Иммунитет к этому заболеванию развивается очень медленно и оказывается неэффективным, что позволяет повторно заразиться малярией сразу после перенесенного заболевания.
Приобретенный иммунитет формируется только после нескольких эпизодов заражения, что может занять несколько лет и требует относительно коротких промежутков между ними. Кроме того, такой иммунитет обладает рядом особенностей:
- Он специфичен для определенного штамма (то есть, защищает только от одного вида возбудителя малярии);
- Он специфичен для определенного этапа болезни;
- Он специфичен для типа плазмодия.
Тем не менее, наличие такого иммунитета значительно облегчает клинические проявления и симптомы болезни в любой ее форме, а также улучшает прогноз. Считается, что слабый иммунный ответ возникает из-за того, что большую часть жизненного цикла паразит проводит внутри клеток организма, оказывая общее угнетающее воздействие на иммунную систему.
Профилактика
Профилактика малярии имеет свои особенности. На сегодняшний день не существует эффективной вакцины, прошедшей клинические испытания, что делает невозможным длительное защитное воздействие от этого заболевания. Более подробно об этом можно узнать в статье «Можно ли сделать прививки от малярии?». Основные меры профилактики в регионах с высоким уровнем заболеваемости направлены на борьбу с переносчиками инфекции. Для их уничтожения применяются химические средства и другие методы. Также используются репелленты для защиты от укусов насекомых.
Что касается медикаментозной профилактики, то она должна назначаться врачом. Некоторые препараты, используемые для лечения малярии, могут быть назначены в меньших дозах для предотвращения заражения. Их принимают ежедневно или раз в неделю, и они могут быть рекомендованы для взрослых. Профилактика для детей представляет собой более сложную задачу и не всегда возможна.
На данный момент для предотвращения заболевания применяются курсовые терапии с использованием таких препаратов, как акрихин, хлорохин и примахин. Аремизинин, который используется в лечении, не применяется для профилактики.
Людям, которые длительное время находятся в зонах, где распространена малярия, рекомендуются препараты на основе мефлохина (Лариам) и доксициклина.
Лечение
Лечение малярии осуществляется с использованием хинина и его производных. Ранее для терапии применялся хлорохин, который отличался меньшим количеством побочных эффектов. Однако вскоре был обнаружен новый штамм паразита, который оказался устойчивым к этому препарату, и поэтому в лечение вновь вернулся хинин. Одной из главных причин опасности малярии является постоянное изменение штаммов и их способность развивать устойчивость к лекарственным средствам. Хинин же остается эффективным против всех известных на сегодняшний день возбудителей.
Кроме того, терапия может включать Доксициклин, Прогуанил, Примахин и другие медикаменты. Более подробную информацию об этом можно найти в статье, посвященной лечению малярии.
Вопрос-ответ
Какие 3 основных симптома сопутствуют малярии?
Симптомы. Наиболее распространенными начальными симптомами малярии являются лихорадка, головная боль и озноб. Симптомы обычно возникают в течение 10–15 дней после укуса инфицированным комаром. У некоторых людей, особенно уже переболевших малярийной инфекцией, симптомы могут иметь слабо выраженный характер.
Какие симптомы характерны для малярии?
Симптомы малярии. У больного отмечаются сухость во рту, тошнота, рвота, диарея, судороги, анемия. Симптомы болезни появляются через 7-15 дней после укуса инфицированного комара. В редких случаях симптомы манифестируют лишь спустя 5-12 месяцев (это характерно для малярии, вызванной P. Vivax и P.
Сколько дней проходит малярия?
Общая продолжительность приступа 6-12 часов, но при тяжело протекающей тропической малярии – до 36 часов. Наступает период спокойствия, длительность которого зависит от вида возбудителя: при трехдневной – 48 часов, четырехдневной – 72 часа. После первых 3-4 приступов отмечается увеличение печени и селезенки.
Каковы особенности тропической малярии?
Тропическая малярия — наиболее тяжелая форма малярии. Инкубационный период колеблется от 8 до 16 дней. За 3-4 дня до развития клинических симптомов могут отмечаться головная боль, утомляемость, тошнота, снижение аппетита. Начальные проявления характеризуются выраженным ознобом, чувством жара, сильной головной болью.
Советы
СОВЕТ №1
Перед поездкой в регионы, где распространена малярия, обязательно проконсультируйтесь с врачом о профилактических мерах. Это может включать прием противомалярийных препаратов и вакцинацию, если таковая доступна.
СОВЕТ №2
Используйте средства защиты от насекомых, такие как репелленты с содержанием DEET, и носите одежду с длинными рукавами, чтобы минимизировать риск укусов комаров, особенно в вечернее и ночное время.
СОВЕТ №3
Если вы заметили симптомы малярии, такие как высокая температура, озноб, головная боль или усталость, немедленно обратитесь к врачу. Раннее обращение за медицинской помощью значительно увеличивает шансы на успешное лечение.
СОВЕТ №4
После возвращения из поездки в эндемичные районы следите за своим состоянием здоровья в течение нескольких недель. Если появятся какие-либо симптомы, не откладывайте визит к врачу, так как малярия может проявиться не сразу.